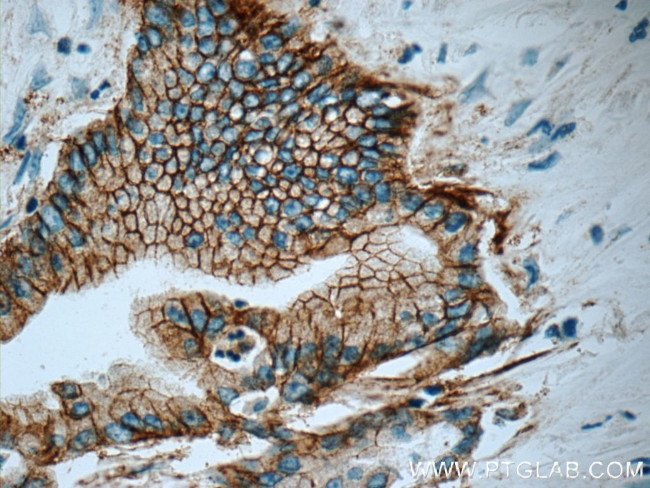
Claudin 18 Antibody in Immunohistochemistry (Paraffin) (IHC (P))
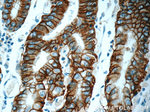
Claudin 18 Antibody in Immunohistochemistry (Paraffin) (IHC (P))

Search
Proteintech
Claudin 18 Monoclonal Antibody (5G7F2)
{{$productOrderCtrl.translations['antibody.pdp.commerceCard.promotion.promotions']}}
{{$productOrderCtrl.translations['antibody.pdp.commerceCard.promotion.viewpromo']}}
{{$productOrderCtrl.translations['antibody.pdp.commerceCard.promotion.promocode']}}: {{promo.promoCode}} {{promo.promoTitle}} {{promo.promoDescription}}. {{$productOrderCtrl.translations['antibody.pdp.commerceCard.promotion.learnmore']}}
产品信息
66167-1-IG
种属反应
宿主/亚型
分类
类型
克隆号
抗原
偶联物
形式
浓度
规格
纯化类型
保存液
内含物
保存条件
运输条件
产品详细信息
Immunogen sequence: TLIGGVMMC IACRGLAPEE TNYKAVSYHA SGHSVAYKPG GFKASTGFGS NTKNKKIYDG GARTEDEVQS YPSKHDYV (185-261 aa encoded by BC146668)
靶标信息
Claudin-18 is a tight junction protein expressed as lung-and stomach-specific isoforms which are generated by alternative splicing of the claudin-18 gene. The lung-specific form is a downstream target gene regulated by the T/EBP/NKX2.1 transcription factor. A splice variant lacking the C-terminal cytoplasmic domain also exists in mouse, but has not been confirmed in human. Human claudin-18 demonstrates 88% amino acid sequence identity to the mouse protein. Immunohistochemical studies have demonstrated complete membrane localization of claudin-18 in lung and stomach epithelial cells, while electron microscopy has shown that it is concentrated in the cell-cell borders of these cells. These features suggest a potentially important role for claudin-18 in the structure and function of tight junctions in the lung and stomach. Claudin-18 expression has also been reported in the inner ear.
仅用于科研。不用于诊断过程。未经明确授权不得转售。
生物信息学
蛋白别名: Claudin-18; surfactant associated 5; surfactant associated protein J; surfactant, pulmonary associated protein J; unnamed protein product
基因别名: CLDN18; SFTA5; SFTPJ; UNQ778/PRO1572
UniProt ID: (Human) P56856, (Mouse) P56857
Entrez Gene ID: (Human) 51208, (Mouse) 56492